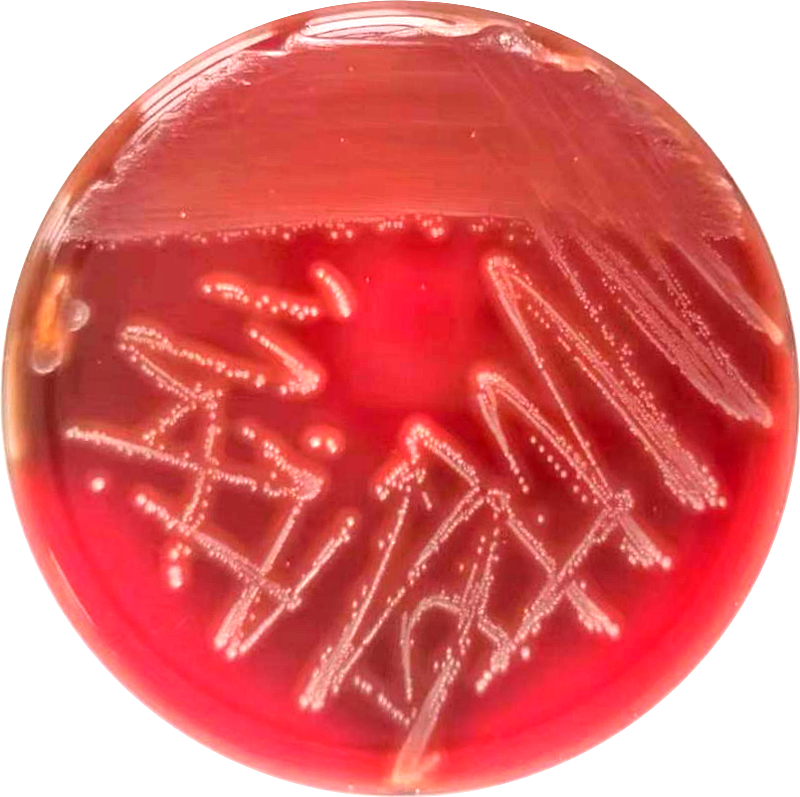

近日,延安市中医医院(北京大学第三医院延安分院)检验科微生物室收到一份来自外科一名男性肛周脓肿患者脓液标本的培养及鉴定。检验科工作人员按照《微生物标本处理程序》对该样本进行处理,经过在血营养琼脂平板上培养24小时后,观察到平板上生长出灰白色、约1mm大小、圆形、表面光滑、有狭窄溶血环的菌落。
经过革兰染色、生化实验及药敏鉴定,高度怀疑为无乳链球菌。因此菌株在我院往年送检标本中检出率较低,这次在肛周脓液样本中检出无乳链球菌也是首次。
为进一步确诊是否为该菌株,在上报常静副主任技师后,检验科补充检测CAMP实验,经过手工检测CAMP实验阳性。(CAMP实验:无乳链球菌能产生CAMP因子,促进葡萄球菌的溶血能力,使两菌交界处出现协同作用而形成箭头状的溶血区。)
最后综合分析,确诊该菌为无乳链球菌,工作人员也尽快将此结果告知临床,检验结果帮助临床明确了诊断,经过对症治疗,患者目前恢复良好,已顺利出院。
一、什么是无乳链球菌?
无乳链球菌,也称B群β溶血性链球菌,是革兰氏阳性细菌,通常定植在胃肠道、会阴和阴道。它们会引发任何年龄患者的侵袭性感染,但常见于新生儿、老年人和有易感因素的成人(如妊娠、糖尿病和免疫力低下)。B族链球菌会引发一系列感染,包括脓毒症、蜂窝织炎、肺炎和脑膜炎。
二、无乳链球菌的病原学特点
细菌及菌落形态:革兰阳性球菌,呈单个、成双、短链状排列。在血琼脂平板上35℃培养18-24h形成灰白色、表面光滑、有乳光、圆形、有狭窄溶血环、直径可达1mm的菌落。
主要生化反应:触酶试验(-)、杆菌肽(-)、CAMP试验(+)。
一份合格的微生物标本不仅可以大大提高微生物病原菌的检出率,而且微生物病原菌检出结果的准确高效,可以为感染性疾病的诊断和治疗尽早提供可靠的依据。
检验科工作人员提醒广大群众:
成年人无乳链球菌感染多发生于机体抵抗力低下时,积极配合治疗均可痊愈。最值得关注的是孕妇生殖道感染无乳链球菌,它可引起泌尿系感染、绒毛膜结膜炎、产褥感染等,也可使新生儿经产道感染无乳链球菌,进而引起菌血症、心内膜炎、皮肤和软组织感染及骨髓炎。所以当孕产妇在孕35周时建议检测无乳链球菌相关检测,如为阳性,积极干预治疗,降低新生儿经产道感染无乳链球菌的机率。

